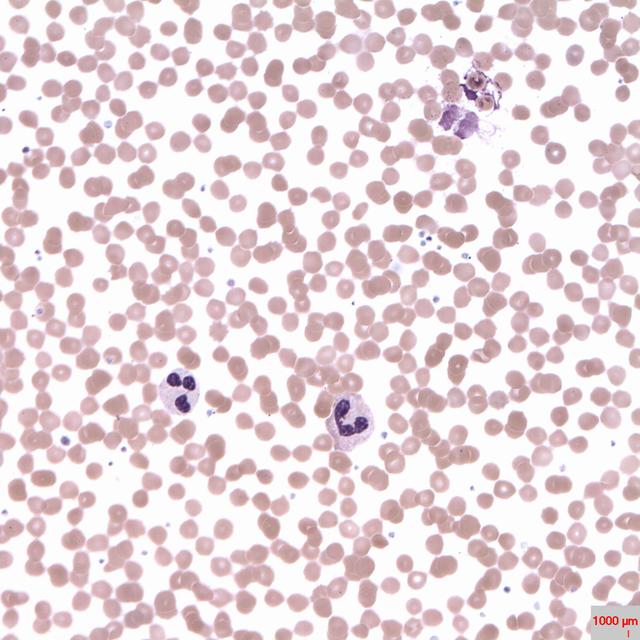
Les polynucléaires sont des globules blancs dont le noyau forme plusieurs lobes. © Prof. Erhabor Osaro, Wikimedia Commons, CC by-sa 4.0

2025-12-12

Après avoir tenté de transplanter de vieilles cellules souches (à l’origine des cellules sanguines) dans une jeune moelle osseuse, des scientifiques testent une nouvelle méthode pour retarder le vieillissement.
Rajeunir le sang de personnes âgées permettrait de ralentir les effets néfastes du système sanguin vieillissant, lequel est vecteur d'un grand nombre de protéines, de cytokines et de cellules. « Et si la meilleure façon de bénéficier des avantages du sang jeune était de rajeunir simplement le système qui fabrique le sang ? », écrivent les chercheurs d'une nouvelle étude publiée dans Nature Cell Biology.
Les scientifiques ont identifié un médicament anti-inflammatoire qui permet de bloquer un signal pathologique libéré par la moelle osseuse endommagée par les années. Pour rappel, les cellules sanguines de l'organisme sont produites à partir d'un petit nombre de cellules souches de la moelle osseuse. Les chercheurs ont découvert que la moelle osseuse vieillissante est submergée par l'inflammation
, ce qui entraîne un dysfonctionnement des cellules souches du sang. Plus une personne vieillit, moins ces cellules souches ne produisent de globules rouges ni de cellules immunitaires.
 Cellules souches sanguines jeunes et vieilles. Le rajeunissement des cellules souches à l'origine de toutes les cellules sanguines pourrait potentiellement ralentir le vieillissement. © Emmanuelle Passegué
Cellules souches sanguines jeunes et vieilles. Le rajeunissement des cellules souches à l'origine de toutes les cellules sanguines pourrait potentiellement ralentir le vieillissement. © Emmanuelle Passegué
Dans le détail, les chercheurs ont identifié chez des souris l'interleukine-1β comme un signal inflammatoire caractéristique du vieillissement et libéré par la moelle osseuse. « Son blocage par le médicament anakinra [utilisé pour le traitement de la polyarthrite rhumatoïde, ndlr] a remarquablement ramené les cellules souches sanguines à un état plus jeune et plus sain », notent les auteurs. Ces derniers veulent maintenant savoir si les mêmes processus sont effectifs chez l'humain, et si le test pourrait être efficace sur des cellules souches plus jeunes.
Partagez sur vos réseaux sociaux :



